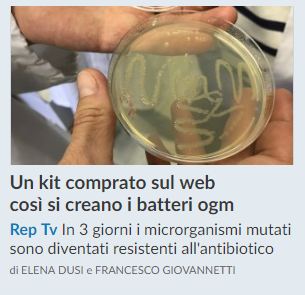
dusi

Il 2019 si è chiuso con la notizia della condanna a tre anni di detenzione per He Jiankui, il ricercatore cinese che ha usato CRISPR per far nascere le prime bimbe con il DNA modificato. Non è chiaro se nel computo sia compreso l’anno già trascorso agli arresti domiciliari da He, che non potrà più svolgere ricerche con embrioni umani e dovrà pagare una multa di 429.000 dollari. Anche due dei suoi collaboratori dovranno scontare una condanna in carcere, ma più breve.
Continua a leggere